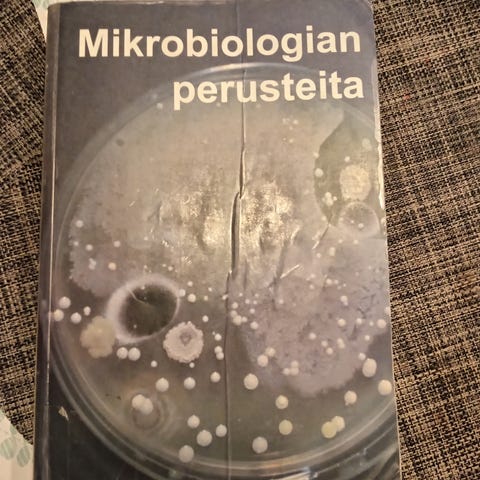
Ilmoituksen kuva

ToriDiili
20 €
Kunto: Hyvä
Aihe: Lääketiede ja terveys
Myydään hyväkuntoinen oppikirja, 4. uudistettu painos, 2016.

Kirjaudu sisään, jos haluat nähdä profiilin ja lähettää viestejä.
Kirjaudu sisäänViimeksi muokattu: 11.10.2025 klo 13.19 ・ Ilmoituksen tunnus: 31544897